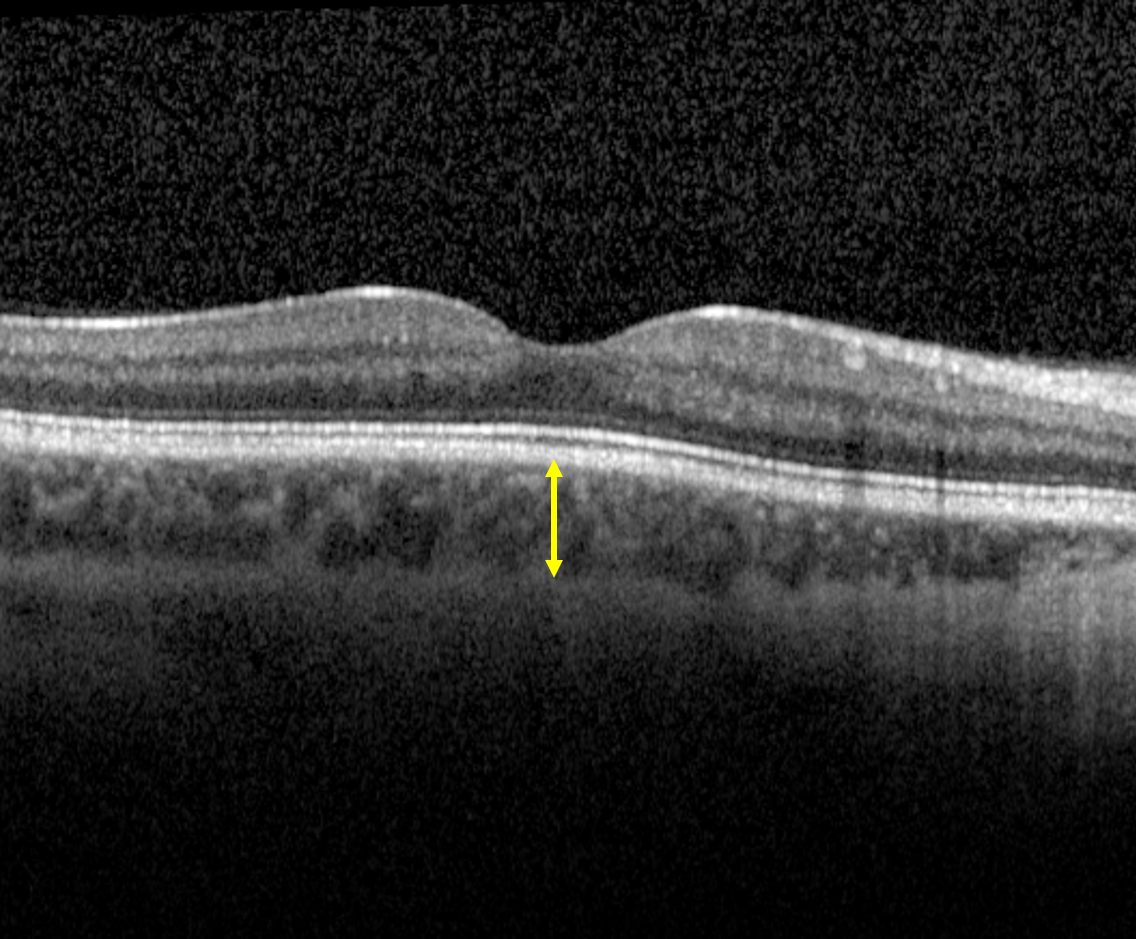

Overview
The choroid supplies blood and nutrients to the outer retina and is composed of several layers:
1. Bruch's membrane: a thin, acellular layer that forms the innermost layer of the choroid. It is involved in the reciprocal exchange between the RPE and choroid.
2. Choriocapillaris: a highly anastamosed layer of capillaries.
3. Sattler's layer: consists of small and medium diameter choroidal vessels
4. Haller's layer: consists of large choroidal vessels. The border between Haller's layer and Sattler's layer is indistinct as there is no established cut-off between medium and large choroidal vessels.
5. Suprachoroidal complex: is the potential space between the choroid and sclera that consists of melanocytes and loose connective tissue. In some cases, accumulation of fluid can occur and separate it from the sclera.
The choroid has a high blood flow which predisposes it to metastatic spread of tumours, infection and inflammatory disease.


